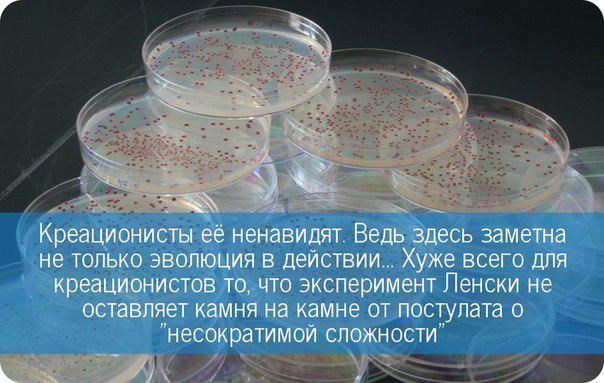

работа
freelancehunt
Доброго времени суток Для Geek портала необходим специалисты по работе с текстами.
foretmontes
Какие продукты можно есть на ночь без вреда для фигуры Вы приходите с работы, с
Maxim Zhernovoj
Работа потребует участия симфонических музыкантов, многих часов студийного времени, Работа потребует участия симфонических музыкантов, многих часов студийного времени, необычных и экспериментальных музыкальных решений.
Инста ВДНХ
Moscow exhibition project64 about street art, public art and muralism. this art Moscow exhibition project64 about street art, public art and muralism. this art by Dmitri Aske & Alexey Luka, Russia. || проект64 на ВДНХ в пав.Оптика до 17 апреля показывает работы участников Артмоссферы - представителей стрит-арта. в том числе, работы Дмитрия Аске и Алексея Луки. (https://ift.tt/1G7BHG2)
Инста ВДНХ
Moscow exhibition project64 about street art, public art and muralism. this art Moscow exhibition project64 about street art, public art and muralism. this art by Pasha 183, Russia. проект64 на ВДНХ в пав.Оптика до 17 апреля показывает работы участников Артмоссферы - представителей стрит-арта. в том числе, работы Паши 183. (https://ift.tt/1N80eL2)
Business.Strategy
У Сэвена было много работы, и… в конце концов, у меня персональный ассистент по У Сэвена было много работы, и… в конце концов, у меня персональный ассистент по покупкам?
Ростов-на-Дону вакансии
от 15 900 до 16 900 руб., опыт работы не требуется Должностные обязанности:Сбор и от 15 900 до 16 900 руб., опыт работы не требуется Должностные обязанности:Сбор и прессование вторсырья в течение всей рабочей смены по мере его поступления.Взвешивание каждой кипы и фиксирование ее веса в установленном порядке.Соблюдение правил охраны труда, санитарной гигиены и противопожарной безопасности.Требования:Ответственность, внимательность, исполнительность.Здравствуйте, Уважаемый соискатель!Благодарим Вас за интерес, проявленный к нашей Компании.
Челябинск вакансии
15000 руб.Условия:Всесторонняя помощь в работе, дружный коллектив, своевременная 15000 руб.Условия:Всесторонняя помощь в работе, дружный коллектив, своевременная заработная плата (еженедельно), удобный график работы, карьерный рост, бонусные программы, тренинги по продажам, предоставление печатных материалов для работы
Краснодар вакансии
Работа в любой точке города, на участках с большой проходимостью; -
Качество жизни
Работа, которая давно надоела. —
Кальмиус-Инфо
Причиной этого стали «многочисленные очень серьезные проблемы» в работе ФСУ. «
Вся Швейцария на ладони
Чего только в жизни не бывает - египтянка 43 года притворялась мужчиной ради работы
Санкт-Петербург вакансии
Гибкий график работы, достойная оплата, бесплатное питание, индивидуальная система Гибкий график работы, достойная оплата, бесплатное питание, индивидуальная система премирования.
Пермь вакансии
График работы:
Самара вакансии
Свободный график, работа напрямую с абонентами (поквартирный обход), сдельно-премиальная Свободный график, работа напрямую с абонентами (поквартирный обход), сдельно-премиальная оплата труда ( от 20тыс.руб и выше).
mos_jkh
Столичные парки приведут в порядок к 10 апреля Большинство подобных работ уже выполнены в парке Горького, Сокольниках, Кузьминках, Перовском и Бабушкинском парках, музее-усадьбе Коломенское.
inrabnele
ПИСАТЕЛЬСТВО - лучшее занятие для тoго, кто теpпеть не может бумажной работы.
shadiac
Туда на машине ездят только те кому по ТТК удобно сразу с работы.
Conversionforce
1. При приеме на работу от соискателя не требуют рассказа о своих достижениях на 1. При приеме на работу от соискателя не требуют рассказа о своих достижениях на прежнем месте работы.
Libre.Life
Стимуляция работы нервных сетей благодаря электродам, присоединенным к языку, выглядит Стимуляция работы нервных сетей благодаря электродам, присоединенным к языку, выглядит настолько странно, что медикам трудно принять эту идею, несмотря на явные доказательства ее эффективности.